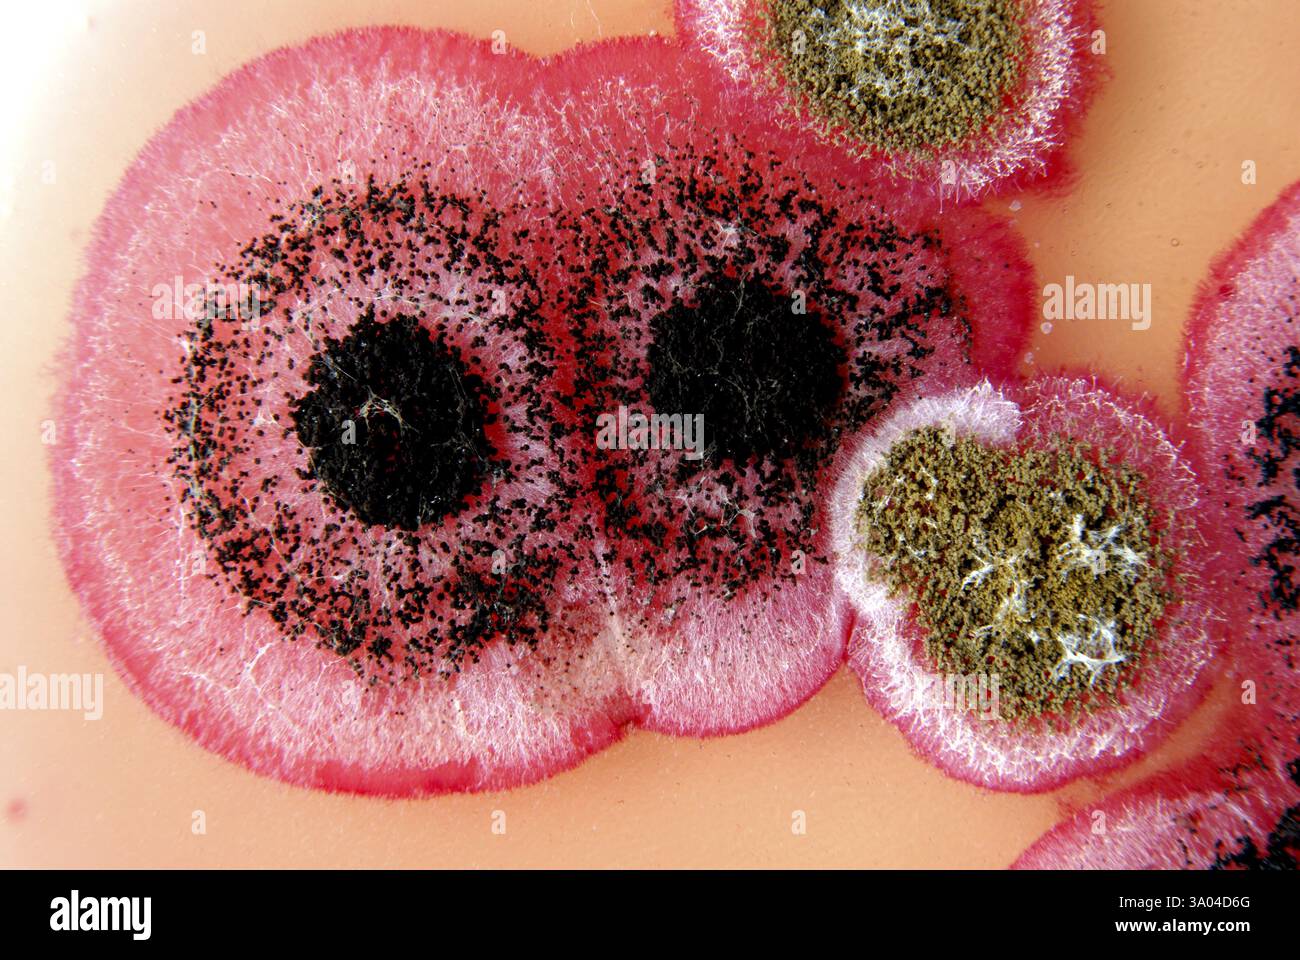
La ricerca scientifica le colonie fungine i semi di cotone su rose bengal agar chloramphenecal Foto Stock

Ricerca scientifica Immagini Stock
(1,495,274)Filtri rapidi:
Ricerca scientifica Immagini Stock

RMC5GYAE–Fraunhofer Umsicht istituto per la ricerca scientifica. La ricerca di Redox-Flow batterie per lo stoccaggio di energia rinnovabile.

RM3A115T6–Vista aerea, Rheinisch-Westfälische Technische Hochschule Aachen, University RWTH Campus Melaten Nord, sede di ricerca scientifica, Campus-Boulevard,

RF2STTA86–La manifestazione "Hands Off Our Healthcare" contro i tagli DEL DOGE alla ricerca scientifica e alla rimozione dei lavoratori federali nel Washington Square Park.
RM3A04D6G–La ricerca scientifica le colonie fungine i semi di cotone su rose bengal agar chloramphenecal

RF3A5W1TT–Amsterdam UMC firma logo sull'ospedale. L'Università di Amsterdam UMC è un centro medico che combina la cura dei pazienti, la ricerca scientifica e l'educazione.

RF2SACJ4T–Un'illustrazione vettoriale di un laboratorio che conduce ricerche scientifiche, sperimentazioni e misurazioni su uno sfondo in stile cartone animato piatto

RF2E4JYR4–Ricerche scientifiche sul trasferimento nucleare in corso su più cellule staminali embrionali in piastra di petri

RF2AYWFN2–scienza, chimica, tecnologia, biologia e medicina. Team di giovani scienziati multietnici che discutono durante la ricerca scientifica

RM2WK2Y99–Modello del satellite spaziale Ariel per la ricerca scientifica. Al di sopra dell'orizzonte terrestre alle stelle. Esperimenti su radiazioni elettromagnetiche e particelle cariche di energia

RF3CJRPPF–Kinnvika Station Research Hut Nordaustlandet Svalbard Norvegia // NORDEAUSTLANDET, Svalbard — Una capanna di ricerca in legno, identificata come stazione Kinnvika, si erge su un paesaggio roccioso e arido sotto un cielo coperto. La stazione si trova a Nordaustlandet, una grande isola dell'arcipelago delle Svalbard in Norvegia. La stazione di Kinnvika, fondata nel 1957 come parte dell'anno geofisico internazionale, è stata un importante centro per la ricerca scientifica artica e la cooperazione internazionale. La sua posizione remota nella parte nord-orientale del Nordaustlandet, caratterizzata da tundra e caratteristiche glaciali, ha fornito un'esperienza unica

RF2EMPAM5–Medico al microscopio. Ricerca scientifica. Apparecchiature mediche. Concetto di ricercatore di laboratorio.

RF2RFXYFE–Nessebar, Burgas, Bulgaria - 08.02.2023, nave bulgara di ricerca scientifica 'St Cyril e Methodius

RM2HN93MC–Il nuovo Jardin Botanique, Bordeaux, su un sito di brownfield vicino al fiume Garonna, ha aperto 2003, per la ricerca scientifica, e come un giardino di piacere

RMC5GY9H–Fraunhofer Umsicht istituto per la ricerca scientifica. La ricerca di Redox-Flow batterie per lo stoccaggio di energia rinnovabile.

RM3A115T8–Vista aerea, Rheinisch-Westfälische Technische Hochschule Aachen, University RWTH Campus Melaten Nord, sede di ricerca scientifica, Campus-Boulevard,

RF2STTAWC–La manifestazione "Hands Off Our Healthcare" contro i tagli DEL DOGE alla ricerca scientifica e alla rimozione dei lavoratori federali nel Washington Square Park.

RF2YEA812–Persone dell'Università di Innsbruck, in piedi all'interno di una grotta di ghiaccio illuminata situata nelle Alpi europee, che svolgono ricerche scientifiche sul ghiaccio...

RF3A5W1W7–Amsterdam UMC firma logo sull'ospedale. L'Università di Amsterdam UMC è un centro medico che combina la cura dei pazienti, la ricerca scientifica e l'educazione.

RF2SACFX8–Un'illustrazione vettoriale di un laboratorio che conduce ricerche scientifiche, sperimentazioni e misurazioni su uno sfondo in stile cartone animato piatto

RF2E4JEMX–Ricerche scientifiche sul trasferimento nucleare in corso su più cellule staminali embrionali utilizzate nella clonazione e nella modificazione genetica

RF2EK9BBW–Illustrazione vettoriale della tecnologia della ricerca scientifica. UX, UI onboarding mobile app page set con test di laboratorio in linea e analisi scientifiche in genetica, simboli di rischio biologico e test sugli animali

RFBX7NK3–Vetreria di laboratorio su sfondo nero e riflessioni sul tavolo - percorso di clipping per vetreria

RFBY5261–Vetreria di laboratorio con liquido trasparente isolate su sfondo bianco - con tracciato di ritaglio

RMBA1P04–Ricerca scientifica biotech Genetics genoma lab la ricerca della sequenza di DNA di biologia molecolare pipetta tubo di campione

RF2RFXYF7–Nessebar, Burgas, Bulgaria - 08.02.2023, nave bulgara di ricerca scientifica 'St Cyril e Methodius

RM2HN93ME–Il nuovo Jardin Botanique, Bordeaux, su un sito di brownfield vicino al fiume Garonna, ha aperto 2003, per la ricerca scientifica, e come un giardino di piacere

RMC5GY97–Fraunhofer Umsicht istituto per la ricerca scientifica. La ricerca di Redox-Flow batterie per lo stoccaggio di energia rinnovabile.

RM3A115NK–Vista aerea, Rheinisch-Westfälische Technische Hochschule Aachen, University RWTH Campus Melaten Süd, University Hospital, ricerca scientifica

RF2STTAY8–La manifestazione "Hands Off Our Healthcare" contro i tagli DEL DOGE alla ricerca scientifica e alla rimozione dei lavoratori federali nel Washington Square Park.

RF2YEA81A–Persone dell'Università di Innsbruck, in piedi all'interno di una grotta di ghiaccio illuminata situata nelle Alpi europee, che svolgono ricerche scientifiche sul ghiaccio...

RF2K2WRP8–Ricercatore con provette per analisi chimiche da laboratorio in vetro con liquido per analisi, medicina, farmaceutica e ricerca scientifica.

RF2XRCPYN–Torino, Italia - 19 ottobre 2021: Giovani ricercatori al lavoro in un laboratorio oncologico dedicato alla ricerca scientifica

RF2SACG6N–Un'illustrazione vettoriale di un laboratorio che conduce ricerche scientifiche, sperimentazioni e misurazioni su uno sfondo in stile cartone animato piatto

RF3B0TKK5–Base Primavera, base argentina e stazione di ricerca scientifica presso Primavera Cove in Antartide.

RF2E1AHKE–Ricerca scientifica sul pianeta ecologia protezione tecnologia illustrazione vettoriale. UX, UI onboarding mobile app page set con line science biotecnologia, eco-friendly riutilizzabile contenitore imballaggio

RFRP71M1–La scienza del mondo giorno illustrazione astratta. Blue gradiente dello sfondo con DNA per la ricerca scientifica celebrazione.

RF2D7N80K–Laboratorio di ricerca scientifica. Equpment e sciensisti di chimica isometrica, concetto di laboratorio farmaceutico. Illustrazione dell'esperimento farmaceutico, isometria di laboratorio con gli scienziati

RMFW7B91–Il cileno Gonzalez Videla ricerca scientifica dalla stazione di Paradise Bay, Penisola Antartica, Antartide.

RMBA1NEX–Ricerca scientifica biotech Genetics genoma lab la ricerca della sequenza di DNA di biologia molecolare pipetta tubo di campione

RF2RFXYF0–Nessebar, Burgas, Bulgaria - 08.02.2023, nave bulgara di ricerca scientifica 'St Cyril e Methodius

RM2HN93M7–Il nuovo Jardin Botanique, Bordeaux, su un sito di brownfield vicino al fiume Garonna, ha aperto 2003, per la ricerca scientifica, e come un giardino di piacere

RMC5GY9Y–Fraunhofer Umsicht istituto per la ricerca scientifica. La ricerca di Redox-Flow batterie per lo stoccaggio di energia rinnovabile.

RM3A115NE–Vista aerea, Rheinisch-Westfälische Technische Hochschule Aachen, University RWTH Campus Melaten Nord, sede di ricerca scientifica, Campus-Boulevard,

RF2STTA9X–La manifestazione "Hands Off Our Healthcare" contro i tagli DEL DOGE alla ricerca scientifica e alla rimozione dei lavoratori federali nel Washington Square Park.

RF2B79579–donna di ricerca bionda con maschera medica che contiene una provetta per test di laboratorio o esperimenti. Concetto di ricerca scientifica, test del virus

RF2K2WR69–Ricercatore con provette per analisi chimiche da laboratorio in vetro con liquido per analisi, medicina, farmaceutica e ricerca scientifica.

RF2XRCPMN–Torino, Italia - 19 ottobre 2021: Giovani ricercatori al lavoro in un laboratorio oncologico dedicato alla ricerca scientifica

RF2SACWEJ–Un'illustrazione vettoriale di un laboratorio che conduce ricerche scientifiche, sperimentazioni e misurazioni su uno sfondo in stile cartone animato piatto

RFRP71NH–La scienza giorno illustrazione astratta. Sfondo con bolle colorate al microscopio per la ricerca scientifica celebrazione.

RF2D7NA4E–Atterraggio di ricerca scientifica. Scienziati in laboratorio farmaceutico, ricercatori in laboratorio con elementi nano. Pagina del vettore medico. Illustrazione dello scienziato di ricerca, esperimento di laboratorio di scienza

RMFW7B7R–Il cileno Gonzalez Videla ricerca scientifica dalla stazione di Paradise Bay, Penisola Antartica, Antartide.

RMBA1Y72–Ricerca scientifica biotech Genetics genoma lab la ricerca della sequenza di DNA di biologia molecolare pipetta tubo di campione

RF2RFXYH9–Nessebar, Burgas, Bulgaria - 08.02.2023, nave bulgara di ricerca scientifica 'St Cirillo e Metodio ormeggiavano a Nessebar

RM2HN93MR–Il nuovo Jardin Botanique, Bordeaux, su un sito di brownfield vicino al fiume Garonna, ha aperto 2003, per la ricerca scientifica, e come un giardino di piacere

RMC5GYB5–Fraunhofer Umsicht istituto per la ricerca scientifica. La ricerca di Redox-Flow batterie per lo stoccaggio di energia rinnovabile.

RM3A115T9–Vista aerea, Rheinisch-Westfälische Technische Hochschule Aachen, University RWTH Campus Melaten Süd, University Hospital, ricerca scientifica

RF2STTAF6–La manifestazione "Hands Off Our Healthcare" contro i tagli DEL DOGE alla ricerca scientifica e alla rimozione dei lavoratori federali nel Washington Square Park.

RF2B7955P–Donna infermiera con maschera facciale che contiene una provetta per test di laboratorio o esperimenti. Concetto di ricerca scientifica, test del virus. Isolato su bianco

RF2K2WR6A–Ricercatore con provette per analisi chimiche da laboratorio in vetro con liquido per analisi, medicina, farmaceutica e ricerca scientifica.

RF2XRCPPY–Torino, Italia - 19 ottobre 2021: Giovani ricercatori al lavoro in un laboratorio oncologico dedicato alla ricerca scientifica

RF2SACFXJ–Un'illustrazione vettoriale di un laboratorio che conduce ricerche scientifiche, sperimentazioni e misurazioni su uno sfondo in stile cartone animato piatto

RFRP71MN–La scienza del mondo giorno illustrazione astratta. Sfondo colorato con bolle sotto il microscopio per la ricerca scientifica celebrazione.

RF2RFXYH2–Nessebar, Burgas, Bulgaria - 08.02.2023, nave bulgara di ricerca scientifica 'St Cirillo e Metodio ormeggiavano a Nessebar

RM2HN93N2–Il nuovo Jardin Botanique, Bordeaux, su un sito di brownfield vicino al fiume Garonna, ha aperto 2003, per la ricerca scientifica, e come un giardino di piacere

RM3A115NN–Vista aerea, Rheinisch-Westfälische Technische Hochschule Aachen, University RWTH Campus Melaten Süd, University Hospital, ricerca scientifica

































